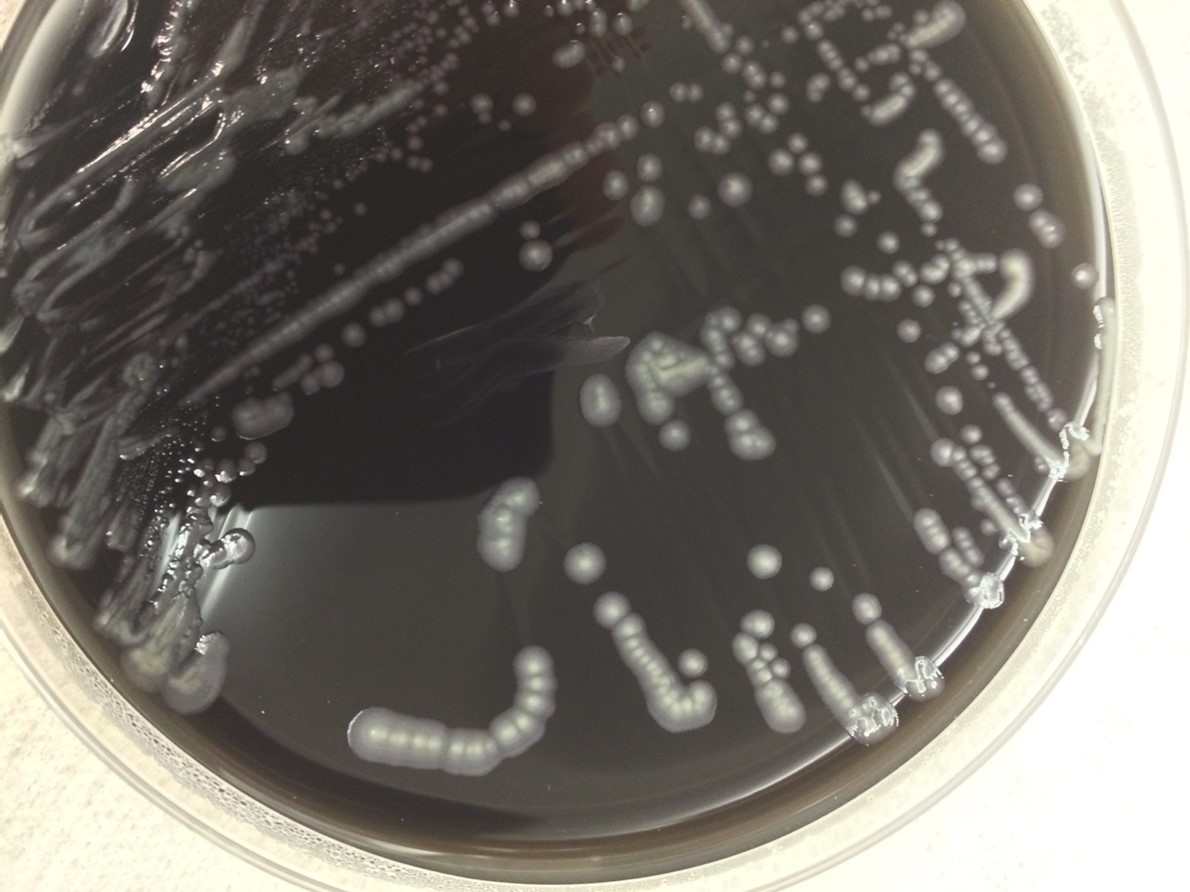
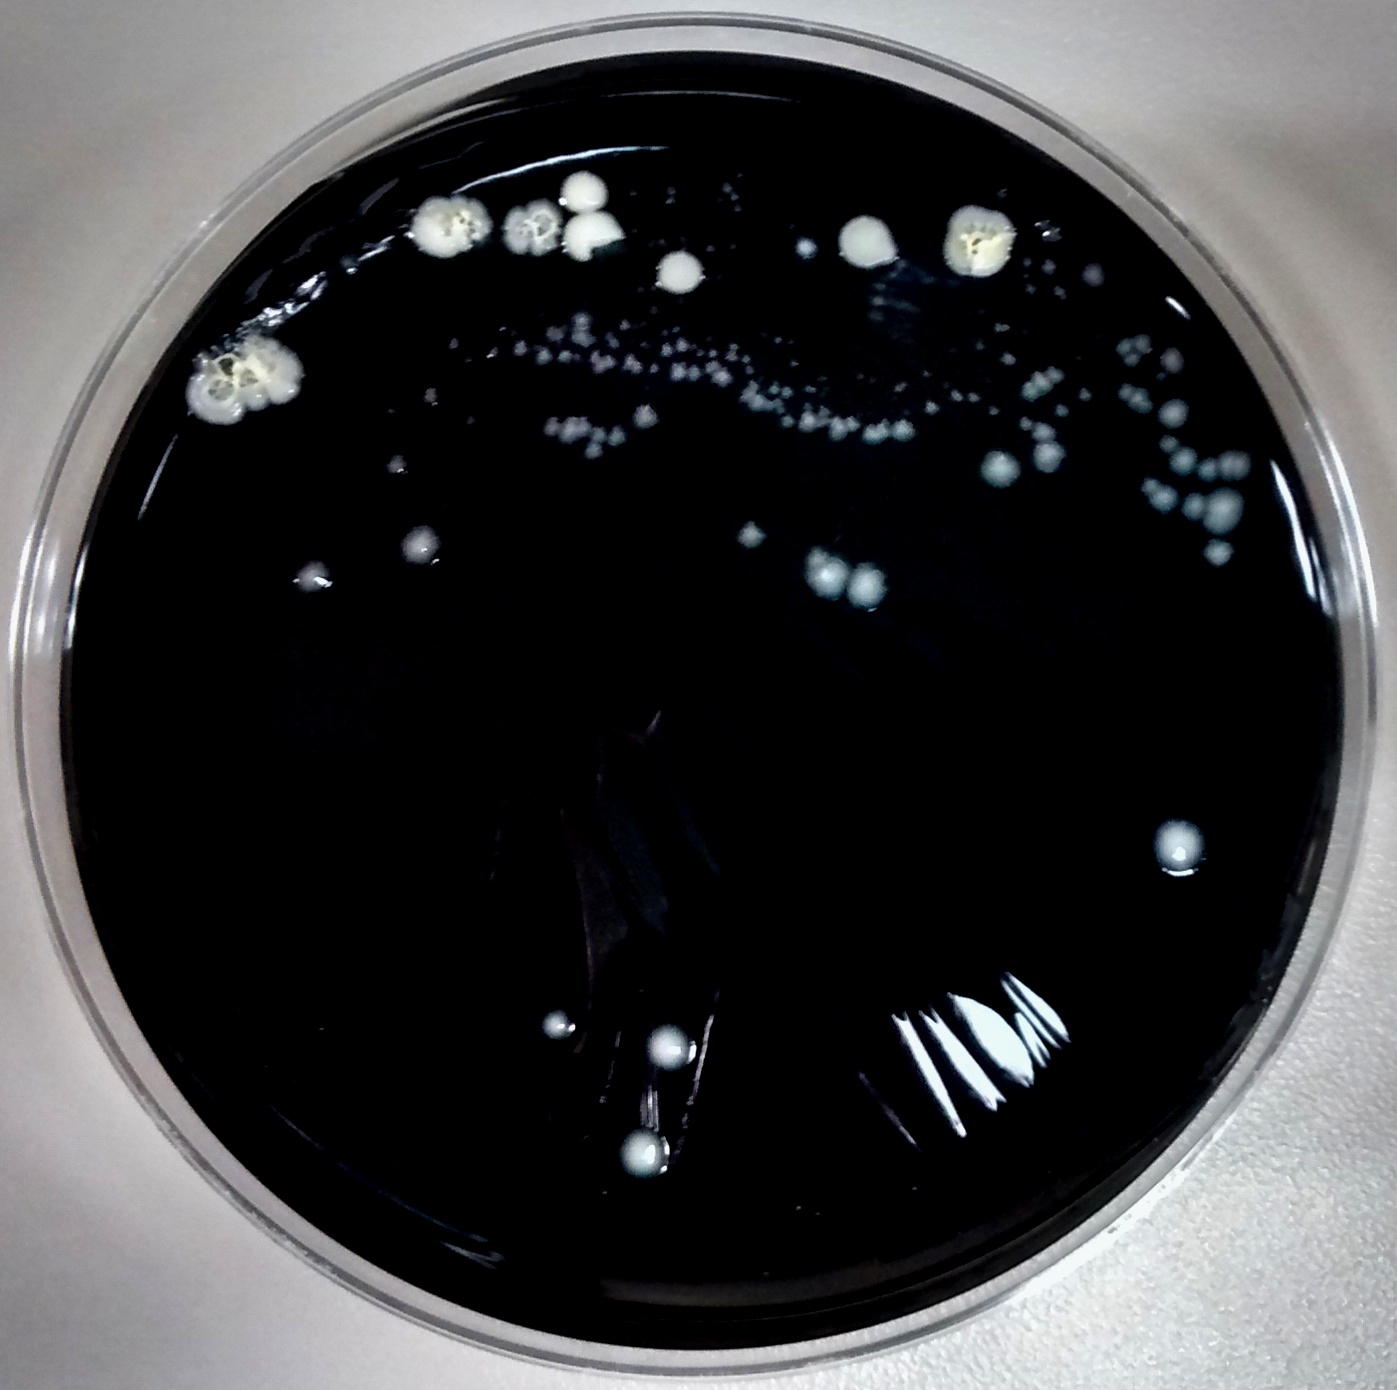
legion1
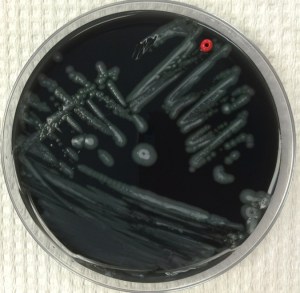
Legionella on BCYE agar plate

Case Description
A 41 year old male with a past medical history significant for HIV presented to the emergency department with complaints of a fever, shortness of breath, cough, myalgias, diarrhea, and dark urine for five days. Upon presentation, he was found to meet sepsis criteria for fever of 105° F, white blood cell count of 19 x 109 /L, and tachycardia. Physical exam was unrevealing. Chest x-ray revealed a lobar pneumonia and a CT chest showed ground-glass opacities with superimposed interlobular thickening and intralobular septal thickening, commonly referred to as “crazy-paving” (Image 1). Initial laboratory assessments included CBC, CMP, blood and sputum cultures, and a T-spot. A legionella urine antigen test was ordered a short time later following an infectious disease consult.
CBC and CMP were significant for leukocytosis (19 x 109 /L), hyponatremia (130 mmol/L), and transaminitis (AST: 97, ALT: 91). Blood and sputum cultures were negative as was the T-spot. Ultimately, the diagnosis of Legionnaire’s Disease was made by the positive urine antigen test.

Discussion
Legionella is a genus of aerobic, gram negative, intracellular pathogens that are most often found in soil and water.1 There are over 60 known species of Legionella with each consisting of a varied number of serogroups. At least 26 of these species are pathogenic in humans, however only a few are responsible for the vast majority of known cases.2 In North America, upwards of 90% of cases are caused by L. pneumophila, and more specifically its serogroup 1. In Australia and New Zealand, L. longbeachae is the predominant human pathogen.3 Legionella infections most commonly cause community-acquired pneumonia after inhalation of aerosols and can less frequently cause a self-limited febrile syndrome known as Pontiac Fever. Characteristic signs that may cause a treating physician to think of Legionella infection include a constellation of symptoms that include diarrhea, hyponatremia, and elevated liver function tests.4
This case reviews a typical presentation of Legionnaire’s disease and highlights several diagnostic pearls worth remembering. Despite commonly being thought of as an exotic pathogen, Legionella is known to cause between 2%-15% of community-acquired pneumonia cases in the United States and Europe.5 The gold standard for diagnosis is culture of lower respiratory secretions, however it is a fastidious organism that is not easily picked up on gram stain or grown on standard media. When culture is attempted, nutrient enriched BCYE agar is required and the timeframe for growth must be increased to 5 to 7 days for L. pneumophila and 14 days for non-pneumophila strains (Image 2).6 Adding to the difficulty in detection, Legionella is easily treated by empiric therapies, such as macrolides, that cover atypical infections; therefore, delays in testing further reduce sensitivity. The urine antigen test does help to overcome this problem as it can detect infection within 2-3 days of symptom onset and remains positive for at least 1 month following resolution of the illness.6
References
- Edelstein PH and Roy CR. Legionnaires’ Disease and Pontiac Fever. In: Mandell, Douglas, and Bennett’s Principles and Practice of Infectious Diseases, 8, Bennet JE, Dolin R and Blaser MJ (Eds), Elsevier, Pennsylvania 2015.
- National Center for Biotechnology Information Taxonomy Browser. https://www.ncbi.nlm.nih.gov/Taxonomy/Browser/wwwtax.cgi?mode=Tree&id=444&lvl=3&keep=1&srchmode=1&unlock (Accessed on April 14, 2021).
- Yu VL, Plouffe JF, Pastoris MC, et al. Distribution of Legionella species and serogroups isolated by culture in patients with sporadic community-acquired legionellosis: an international collaborative survey. J Infect Dis 2002; 186:127.
- Robert R. Muder, L. Yu Victor, Infection Due to Legionella Species Other Than L. pneumophila. Clinical Infectious Diseases. 2002; 35(1):990-998. doi.org/10.1086/342884
- Chahin A, Opal SM. Severe pneumonia caused by Legionella pneumophila: differential diagnosis and therapeutic considerations. Infect Dis Clin North Am. 2017;31(1):111-121. doi:10.1016/j.idc.2016.10.009
- Mercante JW, Winchell JM. Current and emerging Legionella diagnostics for laboratory and outbreak investigations. Clin Microbiol Rev. 2015;28(1):95-133. doi:10.1128/CMR.00029-14
-Allen Green is a first year Clinical Pathology resident at UT Southwestern. He has broad interest in laboratory medicine and Transfusion medicine.
-Dominick Cavuoti is a full professor at UT Southwestern and practices both Medical Microbiology, Infectious Disease Pathology and Cytology.

-Clare McCormick-Baw, MD, PhD is an Assistant Professor of Clinical Microbiology at UT Southwestern in Dallas, Texas. She has a passion for teaching about laboratory medicine in general and the best uses of the microbiology lab in particular.